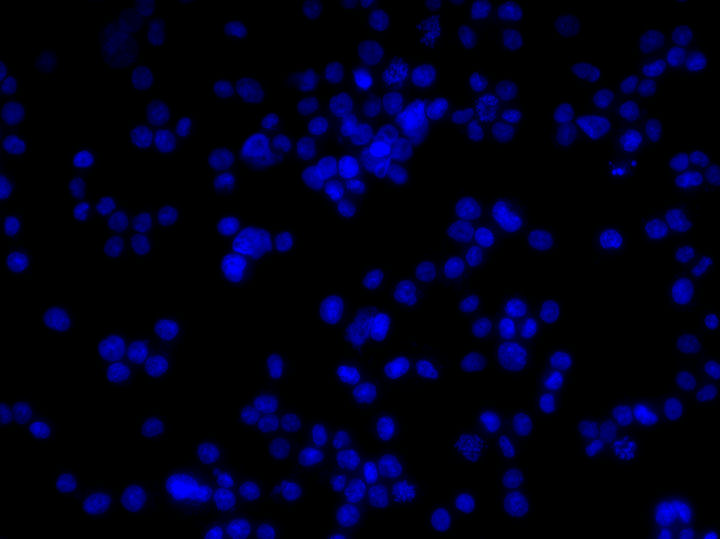
79.jpg 79.jpg
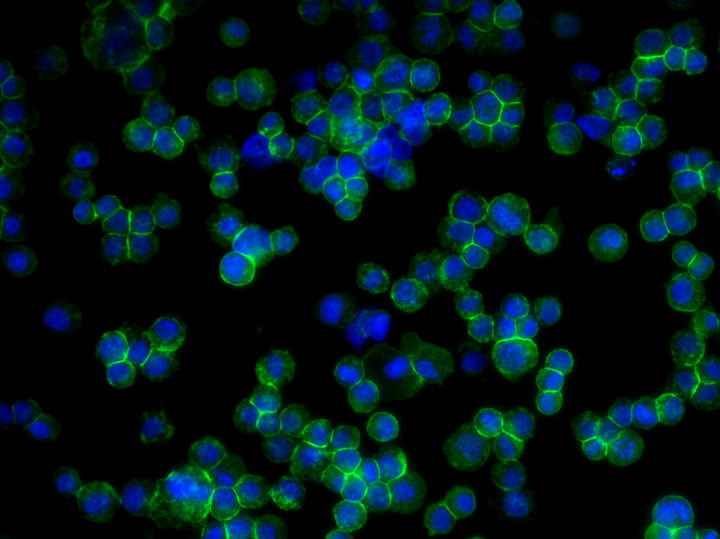
80.jpg 80.jpg

倒置荧光显微镜助力中科院深圳先进技术研究院荧光细胞爬片观察
中科院深圳先进技术研究院利用倒置荧光显微镜成功进行了荧光细胞爬片观察。这项技术有助于科学家更好地了解细胞内部结构和功能,为生物医学研究提供了新的工具和手段。

荧光细胞爬片观察是一种常用的细胞生物学实验方法,用于观察细胞在特定环境下的生长和行为。

中科院深圳先进技术研究院的研究人员发现,使用倒置荧光显微镜MF53-N进行荧光细胞爬片观察可以大大提高实验效率和准确性。倒置荧光显微镜MF53-N具有更宽广的视野和更高的成像质量,使得实验结果更加准确可靠。
在实验中,研究人员将培养皿和荧光细胞爬片放置在倒置荧光显微镜MF53-N的载物台上,并通过显微镜镜头观察爬片细胞生长情况。倒置荧光显微镜MF53-N具有长工作距离、高成像质量,使得细胞内部结构和功能更加清晰可见。此外,该设备还具有更宽广的视野,使得研究人员可以更准确地观察细胞生长情况。
总的来说,倒置荧光显微镜MF53-N是一种重要的生物学实验工具,可以帮助科学家更好地了解细胞内部结构和功能。中科院深圳先进技术研究院的研究人员成功地利用该设备进行荧光细胞爬片观察,为生物医学研究提供了新的工具和手段。
免责声明
本站无法鉴别所上传图片、字体或文字内容的版权,如无意中侵犯了哪个权利人的知识产权,请来信或来电告之,本站将立即予以删除,谢谢。